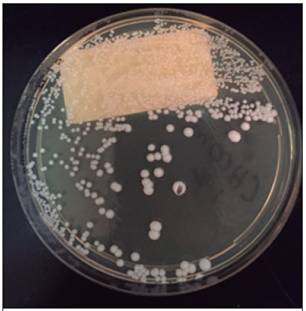
Colonias de Candida famata cultivadas en medio agar de extracto de levadura-peptona-dextrosa (YPD)

Caso clínico
Peritonitis terciaria por Candida famata: infección por una levadura atípica
(Tertiary peritonitis due to Candida famata: Infection by an atypical yeast)
Peritonitis terciaria por Candida famata: infección por una levadura atípica
Acta Médica Costarricense, vol. 59, núm. 1, pp. 35-37, 2017
Colegio de Médicos y Cirujanos de Costa Rica
Recepción: 02 Octubre 2016
Aprobación: 10 Noviembre 2016
Resumen: La Candida famata es una levadura halotolerante, sobreproductora de vitamina B2, asociada infrecuentemente a infecciones en seres humanos, cuyo uso es común en procesos industriales. En nuestro servicio, se había detectado un único caso en el contexto de mediastinitis con un desenlace mortal. Se carecía de experiencia en cuanto al manejo de la infección por este agente. Posterior a una exhaustiva revisión bibliográfica, se demuestra la ausencia de reportes de infecciones por este agente en el contexto de la peritonitis terciaria. Se reporta el caso de un paciente de 37 años de edad que sufrió una herida de arma blanca en abdomen, y que después de múltiples complicaciones asociadas a este evento, desarrolló una peritonitis terciaria por C. famata; fue tratado satisfactoriamente con caspofungina y un abdomen abierto con terapia de presión negativa e instilación. Se espera que esta experiencia sirva de referente al detectar algún paciente con esta condición en el futuro.
Descriptores: peritonitis terciaria fúngica, especies no albicans de Candida, peritonitis por Candida famata.
Abstract: Candida famata is a halotoleran, vitamin B2 overproducing yeast that is rarely associated with infections in humans, but is commonly utilized in industrial processes. In our service, it had been detected only once before in a patient with mediastinitis. The outcome of that infection was fatal. Not only were we unfamiliar with the management of infection by this agent, but after performing a thorough literary review, we were unable to find published reports of infections by this pathogen as the cause of tertiary peritonitis. We report the case of a 37 year old male who after suffering a stab wound to his abdomen and having multiple complications associated with this event, developed tertiary peritonitis by C. famata, that was treated with casponfungin and an open abdomen utilizing negative pressure wound therapy with instillation which yielded a satisfactory response to the therapy. This report may be of use in the event that clinicians are confronted with this condition in the future.
Keywords: Non-albicans Candida species, Candida famata peritonitis, Tertiary fungal peritonitis.
La peritonitis terciaria se define como la persistencia o recurrencia de la peritonitis, ya sea de origen primario o secundario, 48 horas después de un tratamiento aparentemente apropiado.1 Esta entidad se presenta como la complicación más letal asociada a infecciones intraabdominales,2 con una mortalidad reportada de hasta un 64%.3 Las entidades microbianas asociadas a la peritonitis terciara están compuestas principalmente de patógenos oportunistas y nosocomiales,4 en los cuales, por lo general, existe una infección por más de un agente.5 Los agentes aislados con mayor frecuencia en peritonitis tercia son: Enterococcus, Candida sp y Staphylococcus epidermidis.3 La infección por hongos es muy frecuente en conjunto a las sepsis intrabdominales bacterianas, y su hallazgo es casi sinónimo de peritonitis terciaria.
La Candida famata es una levadura halotolerante,6 que sobreproduce la vitamina B26 asociada en principio a la curación de ciertos quesos7 y carnes porcinas,8 pero debido a su alta resistencia a diferentes medios, ha sido adaptada para diversos procesos industriales, tales como la reducción de compuestos tóxicos asociados con la minería,9 la producción de riboflavina10 y la de glicerol.11 Se le conoce también como C. flareri; antes había sido descrita como un teleomorfo de Debaryomyces hansenii, pero estudios posteriores determinaron que eran especies separadas.12 En el contexto de la sepsis intraabdominal por hongos, este patógeno ha sido descrito como contaminante durante diálisis peritoneal continua en pacientes con nefropatías crónicas.13 También se encuentra asociado a múltiples otras manifestaciones, tales como septicemia14 vaginitis15 y onicomicosis16 entre otras.
Figura 1
Colonias de Candida famata cultivadas en medio agar de extracto de levadura-peptona-dextrosa (YPD)

Figura 2
Terapia de abdomen abierto con presión negativa e instilación. Nótese las dos fístulas entéricas conducidas a piel en la porción inferior de la fotografía.
Tras una revisión bibliográfica utilizando Ebscohost, Google Scholar y Pubmed, no se logró encontrar un caso de peritonitis terciaria por este agente.
A continuación se comunica el caso de un paciente de 37 años de edad que posterior a una herida de arma blanca en abdomen y múltiples intervenciones quirúrgicas abdominales, sufrió una peritonitis terciara por C. famata, mientras se encontraba internado en la Unidad de Emergencias Quirúrgicas del Hospital México; su evolución clínica fue satisfactoria. Se espera que esta experiencia sirva como referente al detectarse algún paciente con esta condición en el futuro.
Caso clínico
Se presenta el caso de un paciente masculino de 37 años de edad, conocido sano, que sufrió una herida de arma blanca a nivel de hipocondrio izquierdo. Al paciente se le practicó una laparotomía exploratoria, la cual muestra una lesión de 8 centímetros en la curvatura mayor del estómago, la cual se rafia y se cierra la cavidad abdominal por planos. A las 12 horas de la intervención inicial, el paciente desarrolla un shock séptico, por sepsis intraabdominal, el cual evoluciona a un fallo multiorgánico. El paciente recibe soporte vital con ventilación mecánica, hemodiálisis continua y nutrición parenteral, y es intervenido quirúrgicamente en tres ocasiones adicionales (al segundo, al sexto y al décimo día) para practicarle lavados de la cavidad abdominal, al igual que tratamiento con abdomen abierto con "bolsa de Bogotá". Se instauró un esquema antimicrobiano empírico con cuatro fármacos a dosis plenas: ampicilina, cefotaxime, metronidazol y meropenem.
El primer organismo aislado en la cavidad abdominal del paciente (al cuarto día de internamiento) fue un Enterococcus faecalis, sensible a los carbapenémicos, por lo cual se readecuó el tratamiento antimicrobiano. Igualmente, al sexto día de internamiento, presenta un "Candida score" de 417, por lo que se le inicia tratamiento con anfotericina B.
En el séptimo día de estancia hospitalaria, se obtiene una muestra de líquido peritoneal, la cual cultiva una Candida famata (Figura 1), una especie de Candida que no había sido identificada en nuestro servicio hasta tres semanas previas a este caso, cuando se aisló este hongo en un paciente con mediastinitis18, internado en la misma cama que este paciente. No se efectuó una prueba de sensibilidad antimicrobiana.
Una vez obtenido el diagnóstico de peritonitis terciaria por C. famata, al paciente se le aplicó un esquema de dos semanas de caspofungina, y tratamiento con terapia de presión negativa intraabdominal con instilación (Figura 2), lo cual permitió controlar el foco séptico y revertir el estado clínico. El paciente no requirió más terapia de soporte vital y fue trasladado a cuidados intermedios y, posteriormente, al piso general. La única secuela actual es la presencia de una fístula entérica residual.
Discusión
Las peritonitis fúngicas son altamente letales, más aun, cuando se asocian a pacientes críticos con un abdomen hostil. No existe un consenso acerca de la terapia idónea para el manejo de esta condición. Estudios in vitro muestran que este agente es sensible a la anfotericina B, la micafungina19 y las equinocandinas.20 Los azoles tienen un tasa importante de resistencia,21 por lo cual no se recomienda su uso en estos casos. El paciente respondió apropiadamente al tratamiento farmacológico y el control local mecánico, utilizando presión negativa e instilación. Es importante que en casos futuros, se obtenga un claro perfil de resistencia de este patógeno en el medio, para mejor delinear el esquema terapéutico idóneo. Aunque se desconoce el modo de contaminación del paciente, existe un alto nivel de sospecha de que la colonización sucedió durante su estancia hospitalaria, ya que ocurrió justo posterior al aislamiento de este germen por primera vez en el servicio, pero al no existir datos objetivos que permitan comparar las cualidades de estos agentes, tales como pruebas de sensibilidad antimicrobiana o estudios moleculares, no se puede saber con certeza el origen de la infección.
Las peritonitis por Candida se han convertido en un verdadero desafío para el equipo de la unidad de emergencias quirúrgicas, por lo cual se deben de optimizar las medidas para disminuir las infecciones nosocomiales asociadas a estos agentes, más aun cuando se traten de especies atípicas, que hasta hace poco no se detectaban en el medio. La alta letalidad asociada con las peritonitis fúngicas denota que las estrategias terapéuticas, tanto de tipo antimicrobiano como de soporte vital y nutricional en estos pacientes, no han alcanzado un nivel óptimo y requieren mayor discusión entre la comunidad científica. La experiencia local en el manejo de pacientes con sepsis intraabdominal compleja, enfrenta el hecho de que las infecciones micóticas abdominales se han convertido en una complicación cada vez más común, de difícil manejo y con resultados variados, por lo que se requiere efectuar estudios para determinar su incidencia, al igual que las medidas de prevención y manejo óptimo de estas complicaciones.
Referencias
1. Calandra T, Cohen J. The international sepsis forum consensus conference on definitions of infection in the intensive care unit. Crit Care Med. 2005;33:1538-1548.
2. Weiss G, Meyer F, Lippert H. Infectiological diagnostic problems in tertiary peritonitis. Langenbeck's Arch Surg. 2006;391:473-482.
3. Nathens AB, Rotstein OD, Marshall JC. Tertiary peritonitis: Clinical features of a complex nosocomial infection. World J Surg. 1998;22:158-163.
4. Mishra SP, Tiwary SK, Mishra M, Gupta SK. An introduction of Tertiary Peritonitis. J Emerg Trauma Shock. 2014;7:121-123.
5. Panhofer P, Izay B, Riedl M, Ferenc V, Ploder M, Jakesz R, et al. Age, microbiology and prognostic scores help to differentiate between secondary and tertiary peritonitis. Langenbeck's Arch Surg. 2009;394:265-271.
6. Dmytruk K V., Sibirny AA. Candida famata (Candida flareri). Yeast. 2012;29:453-458.
7. Seiler H, Busse M. The yeasts of cheese brines. Int J Food Microbiol. 1990;11:289-303.
8. Saldanha-Da-Gama A, Malfeito-Ferreira M, Loureiro V. Characterization of yeasts associated with Portuguese pork-based products. Int J Food Microbiol. 1997;37:201-207.
9. Linardi VR, Dias JC, Rosa CA. Utilization of acetonitrile and other aliphatic nitriles by a Candida famata strain. FEMS microbiology letters. 1996; 144:67-71.
10. Dmytruk K, Lyzak O, Yatsyshyn V, Kluz M, Sibirny V, Puchalski C, et al. Construction and fed-batch cultivation of Candida famata with enhanced riboflavin production. J Biotechnol. 2014;172:11-7.
11. Adler LE, Blomberg AN, Nilsson AN. Glycerol metabolism and osmoregulation in the salt-tolerant yeast Debaryomyces hansenii. J bacteriology. 1985;162:300-306.
12. Nishikawa A, Sugita T, Shinoda T. Differentiation between Debaryomyces hansenii/Candida famata complex and Candida guilliermondii by polymerase chain reaction. EMS Immunology &F Medical Microbiology. 1997;19:125-9.
13. Martos PG, de Sola FG, Marín P, García-Agudo L, García-Agudo R, Tejuca F, Calle L. Fungal peritonitis in continuous ambulatory peritoneal dialysis: a 10 cases description. Nefrologia. 2009;29:534-539.
14. Wagner D, Sander A, Bertz H, Finke J, Kern W V. Breakthrough invasive infection due to Debaryomyces hansenii (teleomorph Candida famata) and Scopulariopsis brevicaulis in a stem cell transplant patient receiving liposomal amphotericin B and caspofungin for suspected aspergillosis. Infection. 2005;33:397-400.
15. Luis J, Benavides I, Rodríguez DS, Menchaca RT, González G, González EG, et alEspecies de Candida no albicans en la consulta de ginecologia. Med Univ. 2007;9:161-165.
16. Manzano-Gayosso P, Méndez-Tovar LJ, Arenas R, Hernández-Hernández F, Millán-Chiu B, Torres-Rodríguez JM, et alLevaduras causantes de onicomicosis en cuatro centros dermatológicos mexicanos y su sensibilidad antifúngica a compuestos azólicos. Rev Iberoam Micol. 2011;28:32-35.
17. León C, Ruiz-Santana S, Saavedra P, Almirante B, Nolla-Salas J, Alvarez-Lerma F, et alA bedside scoring system for early antifungal treatment in nonneutropenic critically ill patients with Candida colonization. Crit Care Med. 2006;34:730-737.
18. Sanchez Betancourt AA, Sibaja Alvarez P, Camacho RA, Guevara Espinoza E. Candida famata mediastinitis. A rare complication of open heart surgery. Case report and brief review. IDCases. Elsevier; 2016;5:37-39.
19. Beyda ND, Chuang SH, Jahangir Alam M, Shah DN, Ng TM, McCaskey L, et alTreatment of Candida famata bloodstream infections: Case series and review of the literature. J Antimicrob Chemother. 2013;68:438-443.
20. Pfaller MA, Diekema DJ, Messer SA, Boyken L, Hollis RJ, Jones RN, et alIn vitro activities of voriconazole, posaconazole, and four licensed systemic antifungal agents against Candida species infrequently isolated from blood. J Clin Microbiol. 2003;41:78-83.
21. Zuluaga Rodríguez A, de Bedout Gomez C, Agudelo Restrepo CA, Hurtado Parra H, Arango Arteaga M, Restrepo Moreno Angela, et alSensibilidad a fluconazol y voriconazol de especies de Candida aisladas de pacientes provenientes de unidades de cuidados intensivos en Medellin, Colombia (2001-2007). Rev Iberoam Micol. 2010;27:125-129.
Notas de autor